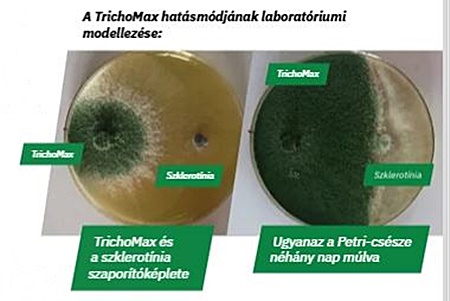
szója

A szójának fontos szerepe van az állatok takarmányozásában, a humán élelmezésben, és nem utolsósorban a gabonafélék egyik legértékesebb előveteménye.
A szója termésátlagait az időjárás, a csapadékmennyisége és eloszlása határozza meg, de a fajtaválasztás, a szakszerű gyomirtás, a technológia betartása és a megfelelő gümőképződés is kulcsfontosságú. Az intenzív szójatermesztésben továbbá elengedhetetlen a TALAJ–NÖVÉNY–KLÍMA rendszer figyelembevétele, ezért a talajminőség javítása kiemelt fontosságú.
Forrás: AGRO.bio Hungary Kft.
A nitrogéngyűjtő gümők jelentősége
A pillangós virágú növények, így a szója is,nitrogéngyűjtő gümők képzésével biztosítják nitrogénellátottságukat. Megfelelő gümőképződés esetén a növény egészségesebben fejlődik, jobb termésátlagot és minőséget eredményez.
A gümő képződését befolyásolja:
- A felvehető nitrogén mennyisége: A túlzott mennyiségű nitrogénműtrágya használata gátolja a gümőképződést. Szójánál az ajánlott mennyiségmaximum 30-50 kg/ha, de megfelelő körülmények között el is hagyható.
- A talajok hőmérséklete és levegőzöttsége: Túl hideg és levegőtlen talajokban nem képez gümőket aszója. 35 °C-os talajhőmérséklet fölött ugyancsak csökken a gümők száma.
- A tápelemek jelenléte: A gümőképződéshez a foszfor, mangán és molibdén szerepe kulcsfontosságú. Kevés, de pozitív tapasztalat van a cink és réz jótékony hatásáról is. A bór utánpótlása pedig javasolt, mert hiánya a fejlődés visszamaradását okozza.
- Növényvédő szerek, gyomirtók: Néhány növényvédő szer jelentősen csökkenti a baktériumok számát, így a rhizobiumokét is.
- Talaj-pH: Megfelelő gümőképződés csak optimális talaj-pH mellett várható, 6-os pH alatt, illetve 7,5-es pH felett csökken a gümők kialakulásának mértéke.
A talajoltás a nagy termések alapja
A szója a nitrogénszükségletének 40-50%-át légköri N megkötésével fedezi. Ha megfelelő a gümőképződés, jelentős mennyiségű N-műtrágya kijuttatása válik feleslegessé. Mivel a szója Magyarországon nem őshonos növény, a gümők kialakulásáért felelős Bradyrhizobium japonicum baktérium sem található meg a talajainkban, ezért kell oltani a szóját.
Az oltott szója vetőmaghasználata mellett a talajoltás még erőteljesebb gümőképződést eredményez. Vagyis a Rhizobium-oltóanyagot nemcsak a magra, hanem a vetés előkészítésekor a talajba is be kell juttatni. A hozam akár 20 százalékkal, a fehérjetartalom pedig 2-3 százalékkal nőhet a talajoltás hatására.
Hogyan segíthetjük a magasabb termésátlagok elérését?
A. Talajoltással fokozhatjuk a szója fejlődését, javíthatjuk a termőképességét
A BactoFil® Szójaoltóban lévő Bradyrhizobium japonicum baktérium gyökérgümőket kialakítva látja el a szóját nitrogénnel, növelve a termésmennyiségét és fehérjetartalmát. A BactoFil® B10 talajoltóval kombinálva a mikroorganizmusok a gyökérzónában megtelepedve támogatják a növény életfolyamatait, javítják a talajszerkezetet, és segítik a szélsőséges klímahatások elviselését.
Hatásuk:
- Jobb gümőkötődés
- Intenzívebb N-kötés
- Magasabb fehérjetartalom
- Jobb termésminőség
- Nagyobb, biztonságosabb hozam
Forrás: AGRO.bio Hungary Kft.
B. Csökkenthetjük a stresszhatásokat
A stresszhatások csökkentik a terméshozamot. Ezért fontos a regenerálódás, az ellenállóképesség és a vegetatív fejlődés támogatása. A stresszkezelésben verhetetlen Algafix élőalgát és kinetint tartalmaz, amely elősegíti a szója fejlődését, fokozza a tápanyagfelvételt és javítja a szárazságtűrést.
- Magas kinetintartalom
- Erősebb hajtásnövekedés
- Jobb stressztolerancia
- Nagyobb és biztonságos termés
- Ellenállóbb növények
C. Kiszoríthatjuk a talajlakó kórokozókat, támogathatjuk a növényegészséget
A szója növényvédelmében a talajban lévő szár- és levélmaradványokról induló kórokozók, például a Macrophomina phaseolina és a szklerotínia, jelentik a legnagyobb kihívást.
Macrophomina phaseolina: Aszályos nyarakon károsít erőteljesen, mikroszkleróciumai akár 4 évig életképesek.
Szklerotínia: Jelentős károkat okozhat,szkleróciumai (a talajban lévő szaporítóképletei)akár 8 évig fertőzőképesek maradnak.
A TrichoMax hatásmódjának laboratóriumi modellezése – forrás: AGRO.bio Hungary Kft.
A TrichoMaxban lévő Trichoderma harzianum gomba hatékonyan csökkenti a talajlakó gombákfertőzési erélyét, támogatja a növény egészségiállapotának megőrzését.
A TrichoMax alkalmazásának előnyei:
- Megváltoztatja a gyökérzónában a mikroflórát, elősegítve a növény fejlődését.
- A Trichoderma harzianum és a kultúrnövény közötti kapcsolat serkenti a gyökérfejlődést és a hajszálgyökér-képződést.
- Javítja a tápanyagfelvételt és a növények védekezőképességét.
- Kontrollálja a talajból támadó gombákat, elvonva a fejlődésükhöz szükséges tápanyagokat, elsősorban a Fe3+ ionokat.
- Enzimatikusan lebontja a növénykárosító gombák szaporítóképleteit, hatékonyan csökkentve a fertőzési nyomást.
Keresse területi szaktanácsadó kollégáinkat, akik készséggel állnak rendelkezésre, akár szakmai segítségre, akár gyors szállításra van szüksége, vagy az aktuális akcióink iránt érdeklődik: http://agrobio.hu/hu/kapcsolat
Daoda Zoltán – Kabai Gábor
AGRO.bio Hungary Kft.
A korábbi TechMag lapszámokat elolvashatod a Magazin rovatban.